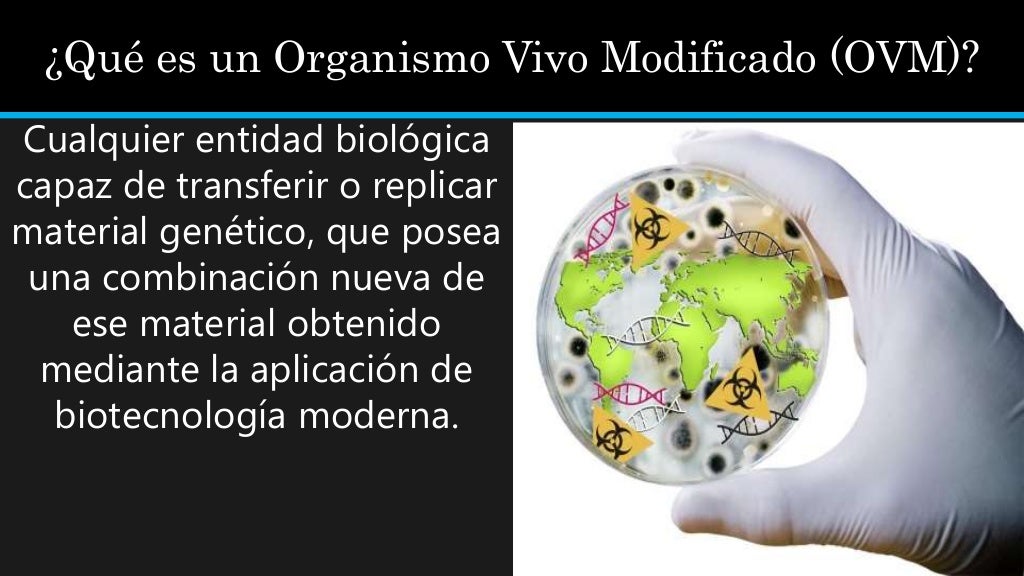

PPT Overview of the Cartagena Protocol & MOPs PowerPoint Presentation ID1607921
El Protocolo de Cartagena fue adoptado como un acuerdo complementario al Convenio sobre la Diversidad Biológica y entró en vigor en septiembre de 2003. El Protocolo busca proteger la diversidad biológica atreves de la administración de los movimientos entre países de organismos vivos modificados (OVM) que resulten de la aplicación de la.

PPT PROTOCOLO DE CARTAGENA SOBRE SEGURIDAD DE LA BIOTECNOLOGÍA PowerPoint Presentation ID509605
El Protocolo de Cartagena (PC) sobre seguridad de la biotecnología es un acuerdo internacional centrado específicamente en el movimiento transfronterizo de Organismos Vivos Modificados resultantes de la biotecnología moderna que puedan tener efectos adversos para la conservación y la utilización sostenible de la diversidad biológica.

Protocolo de Cartagena
El Protocolo de Cartagena promueve la seguridad de la biotecnología mediante el establecimiento de normas y procedimientos prácticos para la transferencia, manipulación y utilización seguras de OVM, con especial atención a la reglamentación de los movimientos transfronterizos de OVM (es decir, movimientos de OVM a través de fronteras, de un país a otro).

Protocolo de Cartagena
PROTOCOLO DE CARTAGENA SOBRE SEGURIDAD DE LA BIOTECNOLOGÍA DEL CONVENIO SOBRE LA DIVERSIDAD BIOLÓGICA TEXTO Y ANEXOS Proto/esp 11/13/2000 3:31 PM Page 181. PROTOCOLO DE. Uno de los asuntos de los que trata el Convenio es el de la seg u r idad de la biotecnolog í a .
Protocolo de Cartagena PDF Biotecnología Organismo genéticamente modificado
La Unión Europea, España y el resto de Estados Miembros son Partes del Protocolo. España fue uno de los primeros países en ratificar el Protocolo de Cartagena, el 16 de enero de 2002. Este instrumento es legalmente vinculante para las Partes Contratantes por lo que constituye el marco mínimo en materia de bioseguridad.
Protocolo de cartagena
El Protocolo se llama Protocolo de Cartagena sobre Seguridad de la Biotecnología por la ciudad de Cartagena, Colombia, que fue el lugar fijado originalmente para su celebración y adopción. La versión final del texto del Protocolo se firmó en enero de 2000 en Montreal y entró en vigor el 11 de setiembre de 2003.
Protocolo de Cartagena y Nagoya PDF Biotecnología Biodiversidad
La Unión Europea, España y el resto de Estados Miembros son Partes del Protocolo. España fue uno de los primeros países en ratificar el Protocolo de Cartagena, el 16 de enero de 2002. Este instrumento es legalmente vinculante para las Partes Contratantes por lo que constituye el marco mínimo en materia de bioseguridad.

PROTOCOLO DE CARTAGENA 1 1 HD YouTube
El Protocolo se llama Protocolo de Cartagena sobre Seguridad de la Biotecnología por la ciudad de Cartagena, Colombia, que fue el lugar fijado originalmente para su celebración y adopción. La versión final del texto del Protocolo se firmó en enero de 2000 en Montreal y entró en vigor el 11 de setiembre de 2003.

Preguntas frecuentes sobre el Protocolo de Cartagena sobre Seguridad de la Biotecnologia CIDOC
Compartir. El Protocolo de Cartagena sobre Seguridad de la Biotecnología del Convenio sobre Diversidad Biológica es un tratado internacional que administra los movimientos de un país hacia otro de organismos vivos modificados (OVMs) que resultan de la aplicación de la tecnología moderna. Fue adoptado el 29 de enero de 2000 como un acuerdo.

Introducción al Protocolo de Cartagena YouTube
Protocolo de Cartagena. El Protocolo de Cartagena sobre Seguridad de la Biotecnología, centrado concretamente en los movimientos transfronterizos, busca proteger la diversidad biológica frente a los riesgos potenciales que presentan los organismos genéticamente modificados que resultan de la aplicación de la biotecnología moderna.

El Protocolo de Cartagena está enfocado en la Seguridad de la Biotecnología aplicada en los
Protocolo de Cartagena. El Protocolo de Cartagena cuyo nombre completo es: Protocolo de Cartagena sobre Seguridad de la Biotecnología del Convenio sobre la Diversidad Biológica es un instrumento internacional que regula los organismos vivos modificados, producto de la biotecnología moderna. Este acuerdo se enfoca específicamente en el.

Implementación del protocolo de cartagena en guatemala
El Protocolo de Cartagena se articula por medio de las decisiones que se adoptan en las Reuniones de las Partes (COP-MOP). En la COP-MOP 5 celebrada en Japón en octubre de 2010, las Partes adoptaron el Protocolo de Nagoya-Kuala Lumpur sobre Responsabilidad y Compensación (PN-KL) Suplementario al Protocolo de Cartagena.
Protocolo de Cartagena Sga Biotecnología Biodiversidad
El Protocolo de Cartagena sobre seguridad de la biotecnología es un acuerdo internacional centrado específicamente en el movimiento transfronterizo de Organismos Vivos Modificados resultantes de la biotecnología moderna que puedan tener efectos adversos para la conservación y la utilización sostenible de la diversidad biológica. Fue adoptado el 29 de enero de 2000 como un acuerdo.

3.1. Protocolo de Cartagena YouTube
Protocolo de Cartagena: Introducción y propósitoEl Protocolo de Cartagena sobre Bioseguridad es un acuerdo internacional que forma parte del Convenio.. Uno de los grandes desafíos que el Protocolo enfrentará en el futuro está ligado a la adecuación frente a las innovaciones en materia de edición genética, como CRISPR-Cas9, que han.

(PDF) EL PROTOCOLO DE CARTAGENA SOBRE SEGURIDAD BIOLÓGICA Y EL COMERCIO INTERNACIONAL Nuevas
El Protocolo de Cartagena sobre Seguridad de la Biotecnología es un acuerdo internacional que se firmó en 2000 y entró en vigor en 2003. Su objetivo principal es proteger la biodiversidad y la salud humana de los posibles riesgos que pueden estar asociados con la liberación de organismos modificados genéticamente (OMG) al medio ambiente.
Objetivo Del Protocolo de Cartagena Biotecnología Ciencias de la tierra y de la vida
El Protocolo de Cartagena sobre Seguridad de la Biotecnología es un acuerdo internacional que tiene como objetivo proteger la biodiversidad y la salud humana de los posibles riesgos que pueden surgir del uso de organismos vivos modificados.. Este protocolo fue adoptado en 2000 y entró en vigor en 2003. Desde entonces, 180 países han firmado y ratificado el acuerdo, comprometiéndose a.
- Star Wars Black Series Leia
- Dibujo Pastel Blanco Y Negro
- Olé El Viaje De Ferdinand Personajes
- Fundamentos Biofisicos De La Electroterapia
- Planta Morada Como Se Llama
- Mi Perro Defeca Negro Y No Quiere Comer
- Cancion De La Piñata Tradicional
- Sandra Echeverria Antes Y Despues
- For Your Eyes Only Letra
- Cuartos De Final Sub 20